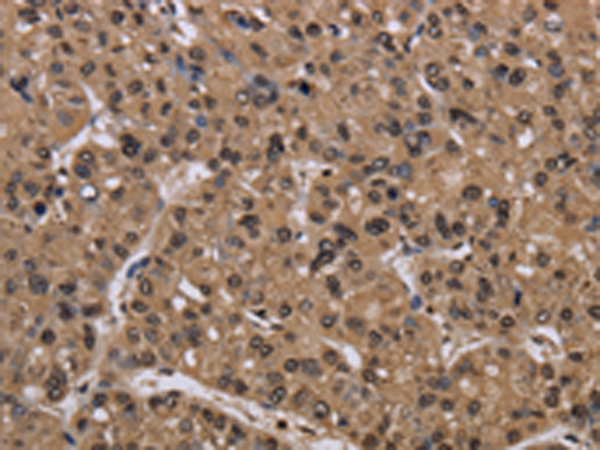
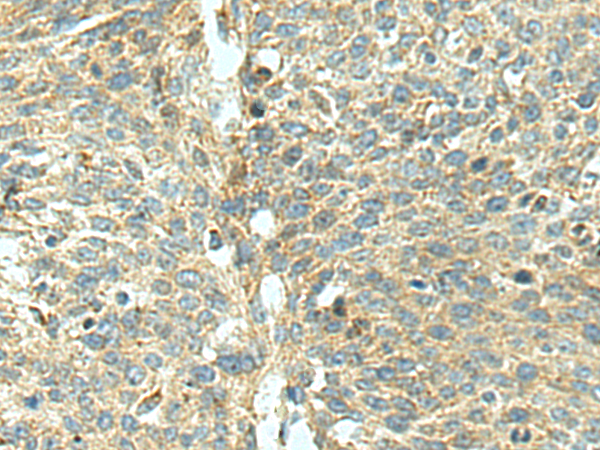

-
分类: 科研抗体货号: P07202别名: CLEC2; CLEC2B; PRO1384; QDED721; 1810061I13Rik应用: IHC反应种属: Human
-
分类: 科研抗体货号: P07179别名: CDC25A2应用: WB,IHC反应种属: Human, Mouse, Rat
-
分类: 科研抗体货号: P07199别名: CKLFSF2应用: IHC反应种属: Human
-
分类: 科研抗体货号: P07223别名: NS5; CRAF; Raf-1; c-Raf; CMD1NN应用: WB,IHC反应种属: Human, Mouse, Rat
-
分类: 科研抗体货号: P07177别名: CDC20A; p55CDC; bA276H19.3应用: WB,IHC反应种属: Human, Mouse, Rat
-
分类: 科研抗体货号: P07198别名: CKII; CK2A1; CSNK2A3应用: WB,IHC反应种属: Human, Mouse, Rat
-
分类: 科研抗体货号: P07222别名: PTX1应用: WB,IHC反应种属: Human
-
分类: 科研抗体货号: P07175别名: BGR; CD369; CANDF4; SCARE2; DECTIN1; CLECSF12应用: WB,IHC反应种属: Human
-
分类: 科研抗体货号: P07197别名: M1; HM1; M1R应用: IHC反应种属: Human, Mouse, Rat
-
分类: 科研抗体货号: P07221别名: 19A; CS1; CD319; CRACC应用: IHC反应种属: Human

鄂公网安备42018502007531号
鄂公网安备42018502007531号

